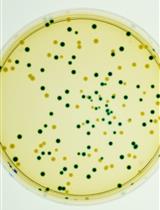
A β-glucuronidase (GUS) Based Bacterial Competition Assay to Assess Fine Differences in Fitness during Plant Infection

Published: Vol 5, Iss 20, Oct 20, 2015 DOI: 10.21769/BioProtoc.1629 Views: 8477
Reviewed by: Samik BhattacharyaDaniel SavatinAnonymous reviewer(s)

Protocol Collections
Comprehensive collections of detailed, peer-reviewed protocols focusing on specific topics
Related protocols
A β-glucuronidase (GUS) Based Bacterial Competition Assay to Assess Fine Differences in Fitness during Plant Infection
Julien S. Luneau [...] Alice Boulanger
Jul 5, 2022 3252 Views

Tomato Stem Injection for the Precise Assessment of Ralstonia solanacearum Fitness in Planta
Yaru Wang [...] Alberto P. Macho
Aug 20, 2021 3758 Views

Botrytis cinerea in vivo Inoculation Assays for Early-, Middle- and Late-stage Strawberries
Piao Yang [...] Ye Xia
Oct 20, 2023 2841 Views
Abstract
We recently established an experimental model system for efficient defense-related cell death using tobacco BY-2 cultured cells treated with culture filtrates of the pathogenic bacterium Erwinia carotovora (E. carotovora) (Hirakawa et al., 2015). Applying this experimental system to transgenic BY-2 cells stably expressing the vacuolar membrane marker GFP-VAM3 (Kutsuna and Hasezawa, 2002) allowed us to monitor changes in vacuolar membrane structures including a decrease of transvacuolar strands during cell death (Hirakawa et al., 2015). Our model system can help to investigate organelle dynamics in defense-related cell death. Here, we show protocol for applying E. carotovora filtrates to BY-2 cells and confocal observation of vacuolar membrane dynamics and subsequent cell death. We used cell cycle synchronized BY-2 cells to effectively monitor invaginated vacuolar membranes such as transvacuolar strands in our recent report (Hirakawa et al., 2015); however, we do not describe the protocol for cell cycle synchronization in this article. For the step-by-step protocol for BY-2 cell synchronization, please refer to previous protocol papers (Nagata and Kumagai, 1999; Kumagai-Sano et al., 2006).
Keywords: Cell deathMaterials and Reagents
Equipment
Procedure
Representative data
The representative time-lapse images of GFP-VAM3 were shown in Figure 1. After the filtrate treatment, the invaginated vacuolar membrane structures including transvacuolar strands gradually decreased (Figure 1). The percentage of transvacuolar strand-less cells reached 12.8±3.00% 4 h after the filtrate treatment while 1.52±1.48% in the mock treatment (Hirakawa et al., 2015).
Figure 1. Time-lapse observation of tobacco BY-2 cells expressing GFP-VAM3 treated with culture filtrates of Erwinia carotovora. Note that the invaginated vacuolar membranes gradually decreased before cell death with cell shrinkage. The time-lapse images were obtained at 5-min intervals for 4.5 h. Scale bar indicates 50 μm.
Notes
You should wait around 10 min after the placement of a microscope glass dish base on the microscope stage to start a time-lapse imaging. The cells would be completely settled down to the bottom while waiting, resulting in appreciated results without the cell displacement.
Recipes
| Yeast extract | 5 g/L |
| BactoTM tryptone | 10 g/L |
| NaCl | 5 g/L |
| Murashige and Skoog plant salt mixture | 4.6 g/L |
| Sucrose | 30 g/L |
| myo-Inositol solution | 200 mg/L |
| Thiamine hydrochloride | 1 mg/L |
| 2,4-Dichlorophenoxyacetic acid | 0.2 mg/L |
| Adjust pH to 5.8 with KOH |
Acknowledgments
The authors thank Dr. Toshihisa Nomura for preliminary experiments on E. carotovora culture filtrates. This work was supported by JSPS KAKENHI Grant Numbers 25711017 (T.H.), 25291056 (S.H.) and 24114007 (S.H.).
References
Article Information
Copyright
© 2015 The Authors; exclusive licensee Bio-protocol LLC.
How to cite
Hirakawa, Y., Hasezawa, S. and Higaki, T. (2015). Vacuole Structure Analysis during Cell Death Subsequent to Application of Erwinia carotovora Culture Filtrates to Cell Cultures of Nicotiana tabacum. Bio-protocol 5(20): e1629. DOI: 10.21769/BioProtoc.1629.
Category
Plant Science > Plant immunity > Disease bioassay
Microbiology > Microbe-host interactions > Bacterium
Microbiology > Microbe-host interactions > Ex vivo model
Do you have any questions about this protocol?
Post your question to gather feedback from the community. We will also invite the authors of this article to respond.
Share
Bluesky
X
Copy link
